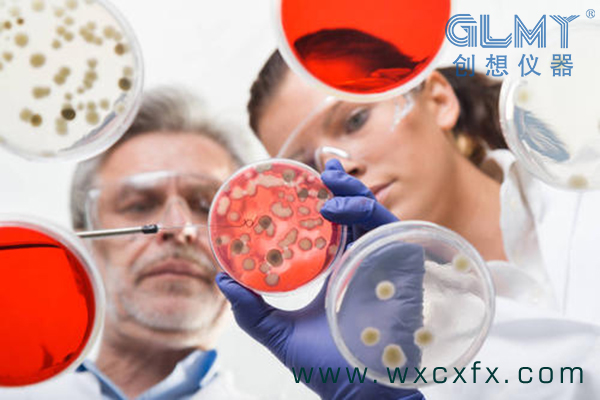

RoHS檢測中,一個重要的儀器就是高效液相色譜儀,那我們需要了解一下的就是高效液相色譜儀的具體應用領域有哪些:
一、藥物分析
合成藥物的純化及質量控制,中草藥有效成分的分離制備及純度測定以及臨床醫學的藥代動力學研究中的分離分析都采用液相色譜儀解決。據報道,除聚合物外,約80%的藥物都能用液相色譜儀進行分離和純化。特別是手性藥物的分離分析,液相色譜儀已引起一個重要的分析方法。
二、食品分析中的應用包括
1.食品本身組成,特別是營養成分,如糖、有機酸、維生素、蛋白質、氨基酸、脂肪的分析。
2.食品添加劑,如防腐劑、抗氧化劑、合成色素、甜味劑和保鮮化學物質的分析。
3.食品污染物,如農藥殘留和黃曲霉素等的分析。
三、在生命科學領域的應用
氨基酸、多肽、蛋白質、核堿、核苷、核苷酸、核酸(RNA、DNA)等重要的生命物質,可以采用液相色譜儀純化和分析測定。
高效液相色譜儀在生命科學領域的應用
四、精細化工產品分析
對于一些具有較高分子量和較高沸點的有機化合物,如高碳數脂肪族或芳香族的醇、醛和酮、醚、酸、酯等化工原料,以及各種表面活性劑、藥物、農藥、染料等化工產品,均可液相色譜儀分析。
五、環境監測中的應用
用于分子量大,揮發性低、熱穩定性差的有機污染物的分離和分析。如多環芳烴、酚類、多氯聯苯、鄰苯二甲酸酯類、聯苯胺類,陰離子和非離子表面活性劑、有機農藥等。它已成為環境科學領域中重要的分析手段。
六、制備分離應用
在許多科學研究和生產領域,往往需要制備或提取一些高純化合物,如新合成化合物的結構鑒定,藥物的生物和毒理試驗,以及某些特殊的標準化合物的制備色譜是一個重要的手段。
以上就是這次創想小編為大家帶來的關于RoHS幫手高效液相色譜儀的相關內容,如果你想了解高效液相色譜儀的更多信息,點這里。
